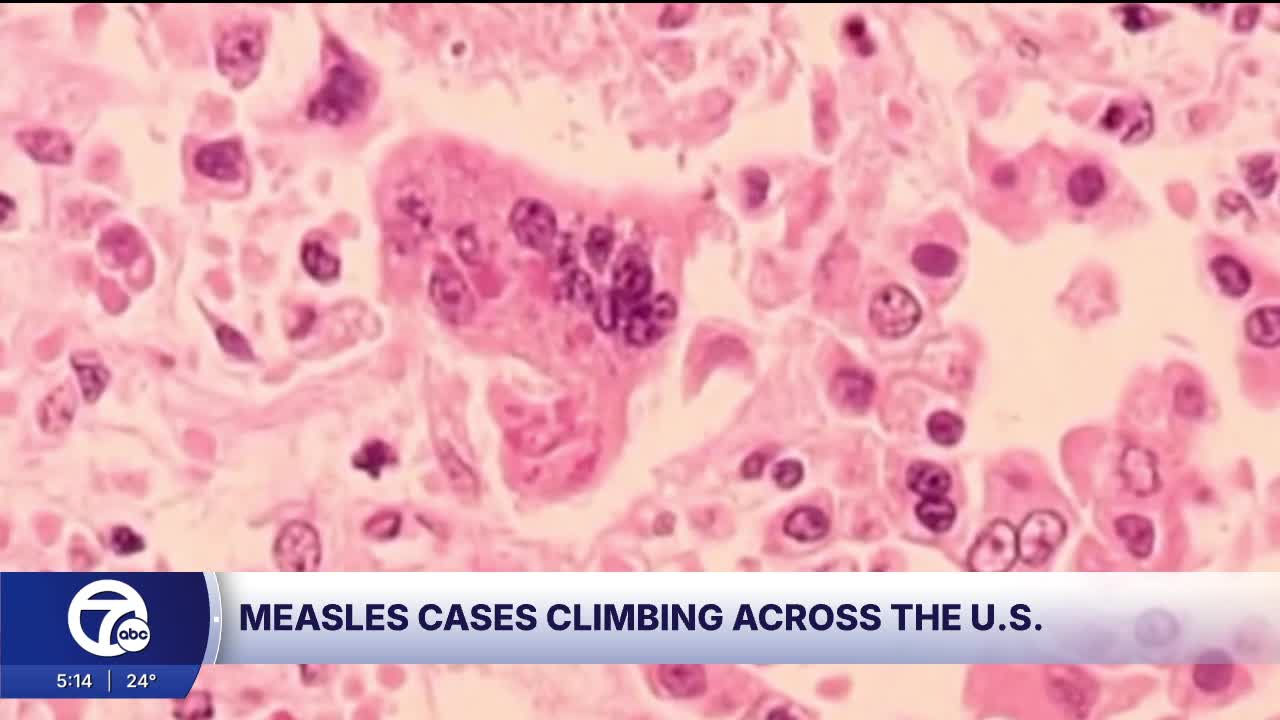

(WXYZ) — In today’s health alert, new CDC data shows measles cases are climbing across the country. The U.S. has already seen roughly four times more cases in 2026 than we usually see in an entire year.
In just a few weeks, there have been at least 733 confirmed measles cases reported nationwide. To put that into perspective, the U.S. averaged about 180 measles cases a year since 2000, when measles was declared eliminated. That said, last year was different, with more than 2,200 cases across 45 states.
Now, what’s driving these outbreaks is where they’re happening. Around 97% are showing up in pockets of unvaccinated or under-vaccinated communities. According to the CDC, children and teens account for 85 percent of all cases, with 203 cases in kids under five and 417 among those ages five to nineteen. Adults make up 13 percent with 93 cases, and another 3%, or 21 cases, are in people of unknown age.
As for which state has the largest outbreak, it’s South Carolina. An outbreak began in the fall, and since then, the state has reported 920 confirmed cases, including 44 new cases last week.
Where does Michigan stand right now, and what should families here be doing to protect themselves? The good news is that Michigan does not currently have any confirmed measles cases in 2026, according to the latest state health updates. But it's still early, and last year we had about 30 measles cases statewide. So, if numbers continue to rise nationwide, we could see more cases here.
So what can we do for protection?
Well, it really comes down to vaccination. The MMR vaccine is about 97 percent effective at preventing measles. For kids, it’s given in two doses - the first after a child turns one, and the second between ages four and six.
Unfortunately, we’re seeing vaccination rates slip. Nationally, MMR coverage among kindergartners has dropped from 95 percent in 2019 to below 93 percent. Herd immunity usually requires about 95 percent coverage.
In my opinion, vaccines are safe, and I’ve chosen to vaccinate my own kids. If parents have questions, please talk with your pediatrician. Adults should also check their immunization records to confirm they’re protected. And, if anyone develops symptoms - a high fever, a cough, a runny nose, red, watery eyes, or a flat red rash - call a healthcare provider before going in, to help avoid exposing others.